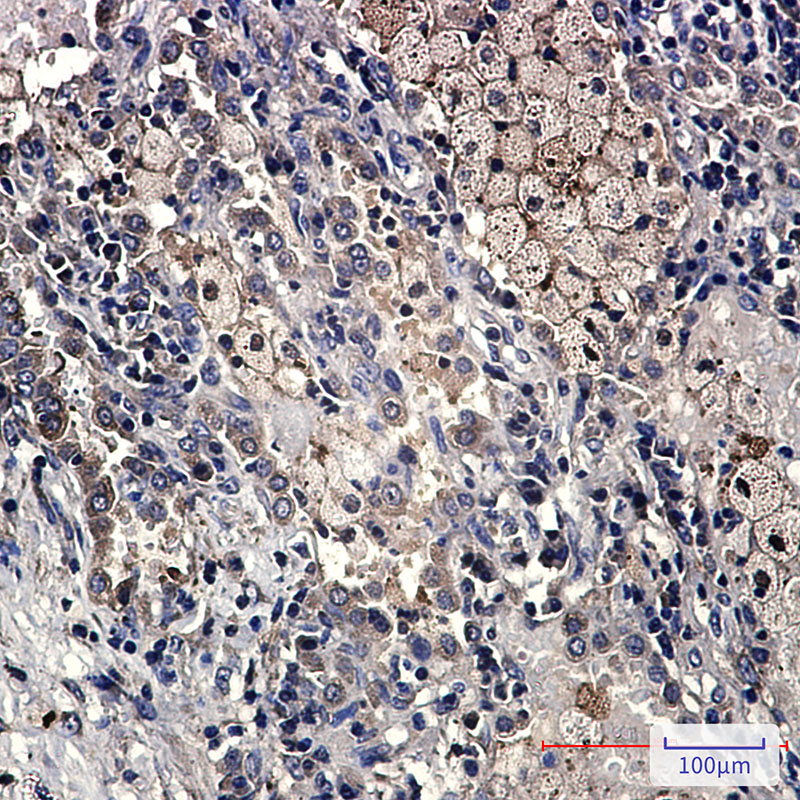

-
分类: 科研抗体货号: P21273别名: CCNE2; G1/S-specific cyclin-E2应用: WB,IHC,IF反应种属: Human
-
分类: 科研抗体货号: P21287别名: Cell proliferation inducing gene 46 protein; Cell proliferation inducing protein 46; Cell proliferation-inducing gene 46 protein; CK 18; CK-18; CK18; CYK 18; CYK18; Cytokeratin 18; Cytokeratin endo B; Cytokeratin-18; K 18; K18; K1C18_HUMAN; Keratin 18; Ke应用: WB,IHC,IF反应种属: Human
-
分类: 科研抗体货号: P21295别名: DAPK2; Death-associated protein kinase 2; DAP kinase 2; DAP-kinase-related protein 1; DRP-1应用: WB,IHC反应种属: Rat
-
分类: 科研抗体货号: P21272别名: CCNE1; CCNE; G1/S-specific cyclin-E1应用: WB反应种属: Human
-
分类: 科研抗体货号: P21285别名: CPR; CYPOR; P450R; por应用: WB,IHC,IF反应种属: Human,Mouse,Rat
-
分类: 科研抗体货号: P21294别名: Death-associated protein 1; DAP-1应用: WB,IP,IHC,IF反应种属: Human,Mouse,Rat
-
分类: 科研抗体货号: P21303别名: TNFRSF10D; DCR2; TRAILR4; TRUNDD; Tumor necrosis factor receptor superfamily member 10D; Decoy receptor 2; DcR2; TNF-related apoptosis-inducing ligand receptor 4; TRAIL receptor 4; TRAIL-R4; TRAIL receptor with a truncated death domain; CD应用: WB,IHC反应种属: Human
-
分类: 科研抗体货号: P21284别名: CPT7; CYP17; P450C17; S17AH; CYP17A1应用: WB,IP,IHC,IF反应种属: Human,Mouse,Rat
-
分类: 科研抗体货号: P21293别名: Rho GDP dissociation inhibitor (GDI) beta; D4; GDIA2; GDID4; LYGDI; Ly-GDI; RAP1GN1; RhoGDI2应用: WB,IHC,IF反应种属: Human
-
分类: 科研抗体货号: P21302别名: ECI1; DCI; Enoyl-CoA delta isomerase 1; mitochondrial; 3; 2-trans-enoyl-CoA isomerase; Delta(3); Delta(2)-enoyl-CoA isomerase; D3; D2-enoyl-CoA isomerase; Dodecenoyl-CoA isomerase应用: WB,IHC,IF反应种属: Human,Mouse,Rat

鄂公网安备42018502007531号
鄂公网安备42018502007531号

